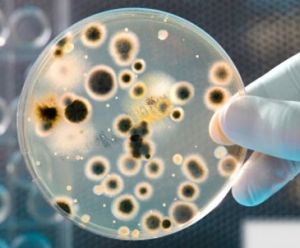
前列腺顆粒細胞 前列腺顆粒細胞

概術
前列腺顆粒細胞前列腺顆粒細胞為體積較大、顆粒較粗的細胞。因脂肪變性或吞噬作用,使胞質內含有多量卵磷脂小體狀顆粒,部分系吞噬細胞。前列腺顆粒細胞在前列腺炎時常伴大量膿細胞出現,部分老年人前列腺液中也較多見。
前列腺液檢查
前列腺液(pristaticfluid)是精液的重要組成部分,約占精液的30%通過前列腺按摩術採集的前列腺液,常常混有精囊液,由按摩時觸及精囊所致前列腺液成分較複雜,含有多種無機離子和有機化合物,其中前列腺特異抗原是前列腺癌的腫瘤標記之一。用於前列腺癌的診斷前列腺酸性磷酸酶更靈敏、特異。此外,前列腺液中還含有淀樣小體,少量上皮細胞和白細胞等有形成分。